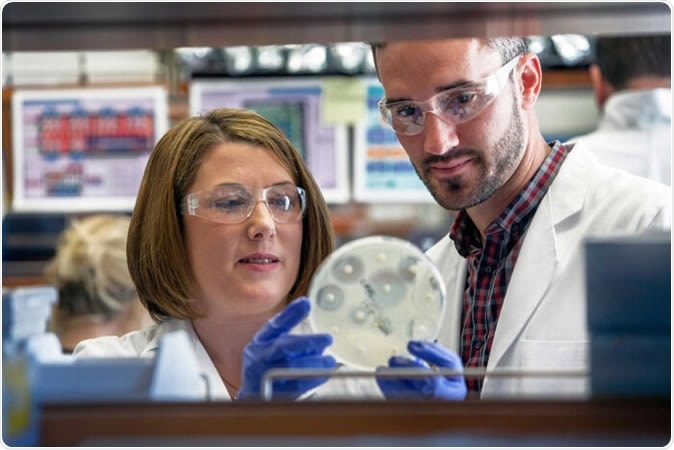
New research led by Washington University School of Medicine in St. Louis sheds light on how the superbug methicillin-resistant Staphylococcus aureus (MRSA) is introduced into households and how it can spread among family members. Shown are the study

New research led by Washington University School of Medicine in St. Louis sheds light on how the superbug methicillin-resistant Staphylococcus aureus (MRSA) is introduced into households and how it can spread among family members. Shown are the study's senior author, Stephanie A. Fritz, MD, (left) and co-author Patrick Hogan. Image Credit: KAREN ELSHOUT

Bacteria Staphylococcus aureus on the surface of skin or mucous membrane, 3D illustration. Image Credit: Kateryna Kon / Shutterstock
MRSA was once a rarest-of-the-rare infection but has today become the cause of over 20,000 deaths. It infects many hundreds of thousands of Americans every year and is difficult to treat because it does not respond to most commonly used antibiotics. Now that it is spreading rapidly, it is important to understand how this happens so that it can be prevented.
Researcher Stephanie A. Fritz says they would see a number of patients from the same family come in with primary or recurrent MRSA infections, within the same year. For this reason, she says, “We felt it was necessary to focus on the specific role that household environments play in MRSA acquisition and transmission.”
The study
The small study looked at 150 children without obvious medical conditions, and their families. The children had a median age of 3 years. They had all been treated for staph infections during the period 2012 to 2015. Their family members numbered almost 700, and there were over 150 pets, either cats or dogs.
Each home was visited 5 times over a full year. The participants answered over 100 questions about their hygiene and other personal habits.
At each visit, the researchers took swabs from the inside of each side of the nose, armpits and groins in humans, and from inside the nose, as well as along the backs of the animals.
They also took swabs from 21 household surfaces that are commonly touched, including the handles of refrigerators, sink faucets, countertops in bathrooms, bedsheets, bath towels, electrical light switches, phones, television or video remotes, and computer peripherals such as the mouse and keyboard.
When they found staph, they examined the molecular fingerprint. This testing of over 3,800 samples of staph helped them classify different strains so that they could find out how each spread, and whether the preferred routes varied from each other. This additional step has not been a component of previous studies, which lumped all the strains together irrespective of their possible origin.
The findings
The researchers found that in about half of the people and 1 in 3 pets, MRSA was present in at least one sample over the study period. Altogether, almost 1,300 episodes of MRSA acquisition occurred. They were especially interested to find that the presence of MRSA was actually lower in cats and dogs than in humans. This suggests that far from acting as reservoirs for the bacteria, “cats and dogs were more likely to get staph from humans than the other way around,” in the words of Fritz.
The strain-wise fingerprinting helped them find how each strain spread, and thus to distinguish between strains coming in from outside the house and those which are transmitted from person to person. In many cases, staph is spread from one person to another, but at the same time, direct spread through contaminated household environments also plays a major role in keeping the chain alive. The study showed that household surroundings were solely responsible for the spread in many cases.
In other words, the chain of transmission of MRSA within a household is almost equally accounted for by new strains that enter the home (510 cases) and the spread of already existing and entrenched strains among the family members (602 cases).
The entry of MRSA into a household
The scientists also analysed health and hygiene habits to find which of these were associated with the entry of staph into the household. They found some important trends:
Frequent handwashing before and after using the bathroom, before eating, before cooking, and after changing a baby’s diaper, using soap or a hand sanitizer, was significantly associated with lower risk of staph entry into the home
The presence of children increased the chances of staph entry, especially if they attended daycare.
Transmission of MRSA in a household
The researchers found that MRSA spread more often in the following situations:
- When household surfaces were heavily contaminated
- The less clean the house, as assessed by obvious smell, clutter and dirty surfaces, the more likely the germ was to spread from one person to another
- Rental and crowded households were more likely to have higher rates of spread
- Sharing bedrooms, beds, towels of any sort, or items used for personal hygiene carried a higher risk of spreading an MRSA strain carried by one of the individuals involved
In such cases, they were more likely to report that they had had staph skin or internal infection between the researchers’ visits.
On the other hand, MRSA transmission was significantly lower if:
- Showering was practiced compared to taking a bath
- Teeth were brushed twice or more a day
- Antibacterial hand soap was used
Prevention of MRSA spread within a family – or elsewhere
The researchers say that transmission within a household is important in the spread of MRSA in a community. Fritz says, “This suggests that aggressive attempts to rid MRSA from household surfaces may significantly lower the number of MRSA infections we’re seeing now.” And co-researcher Patrick Hogan sums up the best lessons from this study: “It’s not a good idea to share personal hygiene items. However, the biggest take home, as cliché as it may sound, is to wash your hands frequently. It offers the best protection from acquiring MRSA.”
Source:
Journal reference:
Longitudinal, strain-specific Staphylococcus aureus introduction and transmission events in households of children with community-associated meticillin-resistant S aureus skin and soft tissue infection: a prospective cohort study Mork, Ryan L et al. The Lancet Infectious Diseases, https://www.thelancet.com/journals/laninf/article/PIIS1473-3099(19)30570-5/fulltext